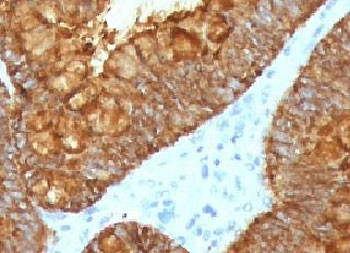
Anti-Aurora B / AURKB, clone ARRK2-2R

Cookie preferences
This website uses cookies, which are necessary for the technical operation of the website and are always set. Other cookies, which increase the comfort when using this website, are used for direct advertising or to facilitate interaction with other websites and social networks, are only set with your consent.
Configuration
Technically required
These cookies are necessary for the basic functions of the shop.
"Allow all cookies" cookie
"Decline all cookies" cookie
CSRF token
Cookie preferences
Currency change
Customer-specific caching
FACT-Finder tracking
Individual prices
Selected shop
Session
Comfort functions
These cookies are used to make the shopping experience even more appealing, for example for the recognition of the visitor.
Note
Show the facebook fanpage in the right blod sidebar
Statistics & Tracking
Affiliate program
Conversion and usertracking via Google Tag Manager
Track device being used
| Item number | Size | Datasheet | Manual | SDS | Delivery time | Quantity | Price |
|---|---|---|---|---|---|---|---|
| NSJ-V7296SAF-100UG | 100 µg | - | - |
3 - 10 business days* |
810.00€
|
If you have any questions, please use our Contact Form.
You can also order by e-mail: info@biomol.com
Larger quantity required? Request bulk
You can also order by e-mail: info@biomol.com
Larger quantity required? Request bulk
1 mg/ml in 1X PBS, BSA free, sodium azide free. Recognizes a protein of 39kDa, which is... more
Product information "Anti-Aurora B / AURKB, clone ARRK2-2R"
1 mg/ml in 1X PBS, BSA free, sodium azide free. Recognizes a protein of 39kDa, which is identified as Aurora B. The serine/threonine protein kinase aurora B (Aurora B) is a chromosomal passenger protein critical for accurate chromosome segregation, cytokinesis, protein localization to the centromere and kinetochore, correct microtubule-kinetochore attachment, and regulation of the mitotic checkpoint. Aurora B forms a tight complex with inner centrosome protein and survivin. Inactivation of any of these proteins causes similar defects in chromosome segregation. A significant overexpression of Aurora B has been found in a variety of human tumors including non-small cell lung carcinoma, astrocytoma, seminoma and carcinomas of the colon, prostate, endometrium and thyroid. The expression level of Aurora B is associated with cell proliferation and prognosis in these tumors. Protein function: Serine/threonine-protein kinase component of the chromosomal passenger complex (CPC), a complex that acts as a key regulator of mitosis. The CPC complex has essential functions at the centromere in ensuring correct chromosome alignment and segregation and is required for chromatin-induced microtubule stabilization and spindle assembly. Involved in the bipolar attachment of spindle microtubules to kinetochores and is a key regulator for the onset of cytokinesis during mitosis. Required for central/midzone spindle assembly and cleavage furrow formation. Key component of the cytokinesis checkpoint, a process required to delay abscission to prevent both premature resolution of intercellular chromosome bridges and accumulation of DNA damage: phosphorylates CHMP4C, leading to retain abscission- competent VPS4 (VPS4A and/or VPS4B) at the midbody ring until abscission checkpoint signaling is terminated at late cytokinesis (PubMed:22422861, PubMed:24814515). AURKB phosphorylates the CPC complex subunits BIRC5/survivin, CDCA8/borealin and INCENP. Phosphorylation of INCENP leads to increased AURKB activity. Other known AURKB substrates involved in centromeric functions and mitosis are CENPA, DES/desmin, GPAF, KIF2C, NSUN2, RACGAP1, SEPT1, VIM/vimentin, HASPIN, and histone H3. A positive feedback loop involving HASPIN and AURKB contributes to localization of CPC to centromeres. Phosphorylation of VIM controls vimentin filament segregation in cytokinetic process, whereas histone H3 is phosphorylated at 'Ser-10' and 'Ser-28' during mitosis (H3S10ph and H3S28ph, respectively). A positive feedback between HASPIN and AURKB contributes to CPC localization. AURKB is also required for kinetochore localization of BUB1 and SGO1. Phosphorylation of p53/TP53 negatively regulates its transcriptional activity. Key regulator of active promoters in resting B- and T-lymphocytes: acts by mediating phosphorylation of H3S28ph at active promoters in resting B-cells, inhibiting RNF2/RING1B-mediated ubiquitination of histone H2A and enhancing binding and activity of the USP16 deubiquitinase at transcribed genes. [The UniProt Consortium]
| Keywords: | Anti-AIK2, Anti-STK-1, Anti-AIM-1, Anti-AURKB, Anti-ARK-2, Anti-Aurora 1, EC=2.7.11.1, Anti-Aurora kinase B, Anti-Aurora-related kinase 2, Anti-Aurora/IPL1-related kinase 2, Anti-Serine/threonine-protein kinase 5, Anti-Serine/threonine-protein kinase 12, |
| Supplier: | NSJ Bioreagents |
| Supplier-Nr: | V7296SAF |
Properties
| Application: | IHC (paraffin) |
| Antibody Type: | Monoclonal |
| Clone: | ARRK2-2R |
| Conjugate: | No |
| Host: | Rabbit |
| Species reactivity: | human |
| Immunogen: | A portion of amino acids 89-251 |
| Format: | Purified |
Database Information
| KEGG ID : | K11479 | Matching products |
| UniProt ID : | Q96GD4 | Matching products |
| Gene ID : | GeneID 9212 | Matching products |
Handling & Safety
| Storage: | +4°C |
| Shipping: | +4°C (International: +4°C) |
Caution
Our products are for laboratory research use only: Not for administration to humans!
Our products are for laboratory research use only: Not for administration to humans!
Information about the product reference will follow.
more
You will get a certificate here
Viewed





